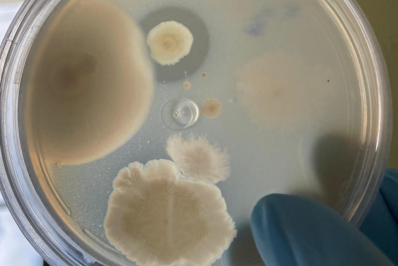
Bactérias da Amazônia podem desenvolver novos medicamentos contra infecções e tumores

"Buiu" ficou conhecida pelo carisma e humorReprodução
Influenciadora 'Buiu a Bonita' morre atropelada na Zona Oeste de Manaus
De acordo com testemunhas, Deusimar teria sido atingida duas vezes por dois veículos diferentes
A influenciadora trans Deusimar Rodrigues de Paiva, de 37 anos, mais conhecida como "Buiu a Bonita", morreu após ser atropelada neste sábado (8), por volta das 21h15, na avenida Coronel Teixeira, no bairro Ponta Negra, Zona Oeste de Manaus. O caso foi registrado na Delegacia Especializada em Homicídios e Sequestros (DEHS).
Deusimar foi atingida ao tentar atravessar a rua com um amigo. De acordo com testemunhas, a influenciadora teria sido atropelada duas vezes, por dois veículos diferentes. Os motoristas não prestaram socorro.
"Buiu" ficou conhecida pelo carisma e humor, chegando a trabalhar como repórter e artista em programas de TV e portais de notícias. A Polícia Civil do Amazonas afirmou que o caso será encaminhado à Delegacia Especializada em Acidentes de Trânsito (Deat), que ficará responsável pela investigação.
Segundo a imprensa local, o velório de "Buiu" ocorre neste domingo (9) na Igreja Evangélica Assembleia de Deus do Pará na Amazônia, no bairro Nossa Senhora de Fátima.

Os comentários não representam a opinião do jornal e são de responsabilidade do autor.